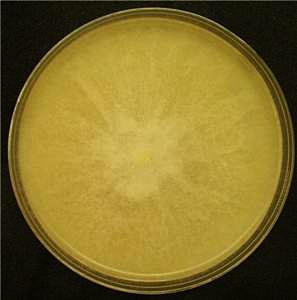
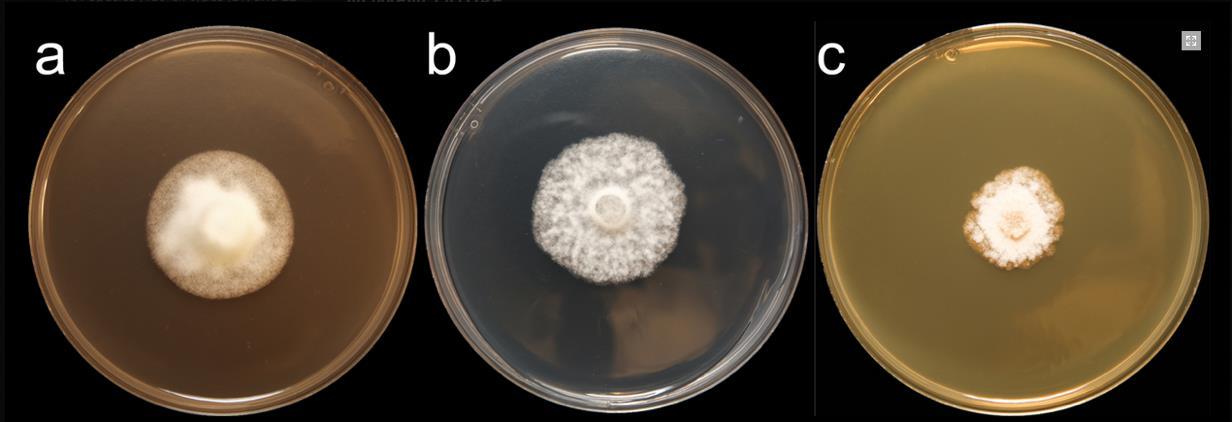
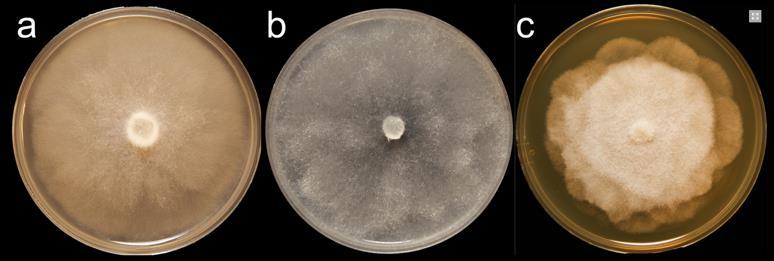
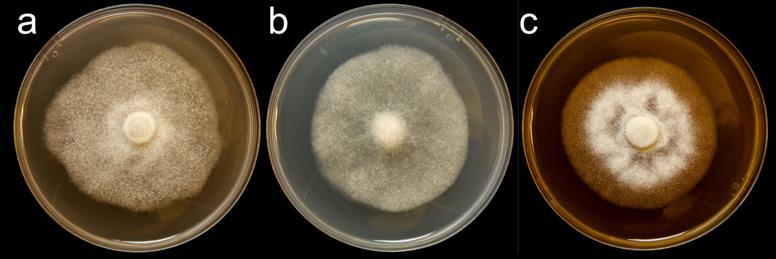
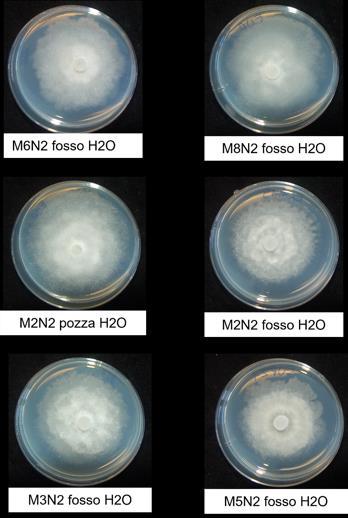
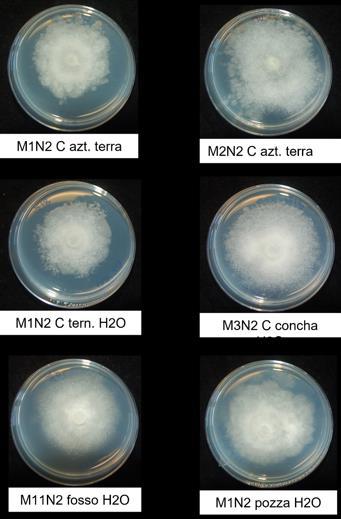
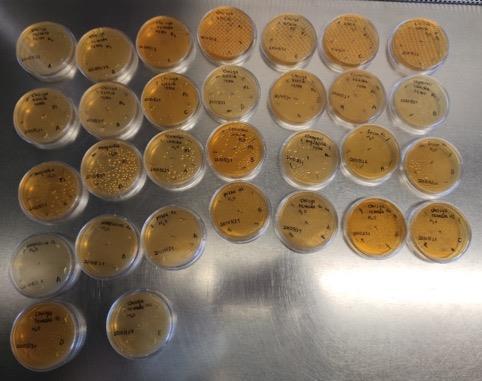

![]()


Il genere Phytophthora dal greco phyto (pianta) e phthora (distruttore), annovera al suo interno alcuni dei patogeni più distruttivi sia in ambiente naturale che vivaistico.
Questi microrganismi vengono erroneamente inseriti tra gli organismi fungini.
Studi hanno dimostrato la loro sostanziale diversità dai miceti, tanto che di recente sono stati classificati
nel Regno dei Straminipila.


PROBLEMA ANTICO: nel 19° secolo, il patogeno Phytophthora infestans causò una grande carestia in Irlanda e in altre aree dell'Europa occidentale.
Illustrazione del 1846 che mostra un ragazzo e una ragazza affamati mentre rastrellano il terreno durante la carestia delle patate irlandese, iniziata negli anni Quaranta del XIX secolo.



Le Phytophthorae appartengono alla classe degli Oomiceti: organismi che presentano numerosi caratteri morfologici e biochimici differenti dai funghi veri e propri.

Ife diploidi con pareti cellulari costituite da cellulosa, anziché ife aploidi con pareti cellulari chitinose
tipiche dei funghi

Le Phytophthorae vengono anche indicate col termine “water molds” (muffe d’acqua), per sottolineare due dei caratteri distintivi di questi microrganismi:
- la predilezione a vivere in ambienti umidi
- la differenziazione di strutture riproduttive molto simili a quelle delle alghe



Principali caratteri distintivi tra Oomiceti (Regno Straminipila) e funghi (Chytridiomycota, Zygomycota,Ascomycota, Basidiomycota)

Le specie di Phytophthora sono eterotrofe e saprofite.
Crescono su substrati di coltura selettivi.

In natura non sono in grado di competere con altri microbi del suolo e quindi possono essere considerati patogeni obbligati.
Ciclo biologico costituito da uno stadio vegetativo di tipo miceliare e dalla formazione di strutture di resistenza, quali:
- i rigonfiamenti ifali (hyphal swelling) - le clamidospore - le strutture riproduttive: sporangi, zoospore e oospore

Nello specifico, ognuna di queste strutture assolve a differenti funzioni biologiche: - rigonfiamenti ifali: si formano nel micelio, forme variabili a seconda della specie. Funzione non ancora ben conosciuta, probabilmente costituiscono degli organi di conservazione. - le clamidospore: tipiche strutture di resistenza con pareti cellulari spesse. Garantiscono la sopravvivenza della specie nel terreno. Si formano nel micelio con forme e dimensioni simili fra le varie specie. La forma e la dimensione delle clamidospore può rappresentare un carattere diagnostico informativo.

Nello specifico, ognuna di queste strutture assolve a differenti funzioni biologiche: - gli sporangi: strutture di moltiplicazione agamica più caratteristiche. La morfologia degli sporangi varia considerevolmente tra le diverse specie e rappresenta un elemento tassonomico molto importante per l’identificazione. La germinazione degli sporangi può avvenire tramite la produzione di zoospore e/o anche direttamente attraverso un tubulo germinativo. - Le zoospore: sono delle strutture biflagellate senza parete esterna. Con condizioni ambientali favorevoli emettono un tubulo germinativo. Le zoospore costituiscono il principale propagulo infettivo del genere Phytophthora ed esibiscono un comportamento chemiotattico che gli permette di trovare il sito ottimale per l’infezione nella pianta ospite (es. ferite o apici radicali)

- le oospore: sono le spore sessuali che derivano dalla fusione tra i nuclei aploidi delle due strutture sessuali specializzate (oogoni e anteridi). Le oospore sono caratterizzate dall’avere una parete particolarmente spessa che consente a queste strutture di superare condizioni ambientali sfavorevoli.

Propaguli di Phytophthora spp.: clamidospore (a), sporangio papillato (b), oogonio, oospora e anteridio anfigino (c). Barra = 20 µm

Ciclo biologico della peronospora della patata, causata dai Phytophthora infestans:
Ciclo biologico complesso, con la formazione di due tipi di spore: le zoospore, prodotte per via agamica e le oospore, prodotte per via sessuale.
Inoculo primario: dà l'avvio alle infezioni, inizia da:
- tuberi infetti
- dai residui di vegetazione sul terreno - da piante spontanee infette, dove il patogeno sverna come micelio - dal terreno infetto

Ciclo biologico della peronospora della patata, causata dai Phytophthora infestans:
Il ciclo vitale del patogeno è caratterizzato da tre fasi:
- formazione del micelio nella pianta ospite
- espansione del patogeno nella pianta ospite
- formazione e dispersione delle spore
Le prime infezioni si hanno sulle foglie vicine al terreno, tramite le zoospore liberate dagli zoosporangi, a loro volta prodotti dal micelio svernante.

Ciclo biologico della peronospora della patata, causata dai Phytophthora infestans:
Zoospore:
- muovendosi in un velo d'acqua, raggiungono la vegetazione
- si incistano sulla superficie del vegetale, germinano attraverso un tubulo germinativo che penetra attraverso gli stomi o per perforazione della cuticola.
Una volta all'interno della pianta il micelio cresce sia intercellularmente che intracellularmente.













































































































































FATTORI CHE HANNO CONTRIBUITOAD INCREMENTARE IL NUMERO DI SPECIE NEL NOSTRO PAESE:
Necessità di diversificare le produzioni

Nuove specie vegetali provenienti da paesi stranieri
Con le piante in vaso, sono state introdotte accidentalmente specie esotiche di Phytophthora
Insufficienza di misure di profilassi, adeguati controlli e monitoraggi fitosanitari sul materiale di propagazione, sui terricci e i substrati colturali
Forzatura, promiscuità e l’impiego di tecniche colturali che favoriscono lo sviluppo di questi patogeni
FATTORI CHE HANNO CONTRIBUITOAD INCREMENTARE IL NUMERO DI SPECIE NEL NOSTRO PAESE:

la diffusione di specie e di varietà di piante non selezionate per la resistenza a questi patogeni
le caratteristiche biologiche ed epidemiologiche di alcune specie di Phytophthora: polifagìa o la capacità di produrre strutture di conservazione e/o di disseminazione
FATTORI CHE HANNO CONTRIBUITOAD INCREMENTARE IL NUMERO DI SPECIE NEL NOSTRO PAESE:

P. palmivora: è stata segnalata come agente causale di macchie brune fogliari e marciume del germoglio centrale (bud rot) di piantine di Chamaedorea elegans (palma della fortuna) allevate in vaso e successivamente è stata identificata come agente di “bud rot” di piante in vaso di Phoenix canariensis (palma delle canarie).

Esempi di nuove specie introdotte in Italia sono:
- P. palmivora: agente causale di black pod e cancro del cacao, black stripe e cadute foglie del caucciù, marciume delle gemme del cocco, marciume dei frutti e del fusto del pawpaw, marciume radicale e damping off delle piantine
- P. cinnamomi: agente causale di marciumi radicali, mal dell’inchiostro del castagno insieme a P. cambivora. - P. ramorum: patogeno forestale aggressivo, causa della morte improvvisa delle querce; originariamente descritto come una peronospora dei ramoscelli e dei rami di Rhododendron.

AGENTI DI MARCIUME RADICALE E DEL COLLETTO: una delle malattie più diffuse nei vivai di piante ornamentali, e sotto certi aspetti anche meno nota.
In passato, i danni causati dalle infezioni radicali di Phytophthora spp. nei vivai sono stati sottovalutati: scarse conoscenze su questo patogeno per la difficoltà di diagnosi relativa alla mancanza di sintomi specifici.
Patogeni presenti sia nel terreno che nelle acque.
In Italia: più di 20 specie rinvenute negli ultimi anni nei vivai di piante ornamentali.
La maggior parte sono specie nuove o segnalate per la prima volta su nuovi ospiti.
Tra le specie di Phytophthora più segnalate in ambiente vivaistico troviamo:
- P. nicotianae
- P. hedraiandra
- P. cactorum
- P. cinnamomi
- P. palmivora
- P. cryptogea TUTTE

Le Phytophthorae nel loro luogo di origine non costituiscono necessariamente un problema: co-evoluzione del binomio patogeno-ospite.

Le piante ospiti autoctone hanno sviluppato difese specifiche che conferiscono una certa tolleranza nei confronti del patogeno.
Quando l'agente patogeno viene trasferito in un nuovo habitat con condizioni favorevoli: possibile estensione a vasta gamma di nuovi ospiti.
IMPORTANTE: l'alta specializzazione e l'intensificazione della produzione vivaistica favorisce la riproduzione e l'ibridazione di specie invasive, aumentandone la dispersione e l'insediamento negli ecosistemi naturali.















DIFFICOLTÀ DI DIAGNOSI: isolamento dai tessuti infetti difficoltoso, è necessario
ricorrere all’impiego di substrati selettivi.
Colonie di Phytophthora ramorum coltivate per 7 giorni su (a) V8® Agar, (b) potato dextrose agar e (c) malt extract agar

Inoltre: frequenti i casi di piante ornamentali, ma non solo, con infezioni radicali di
Phytophthora spp. associate a quelle di altri funghi terricoli che ne nascondono la presenza.


Un esempio:
- le infezioni di P. nicotianae e di P. multivora sulle piantine di Polygala myrtifolia in vaso possono passare inosservate per la concomitante presenza del marciume radicale e del colletto da Cylindrocladium pauciramosum, patogeno ubiquitario nei vivai in cui si coltiva questa specie.
- Analogamente, su mirto le infezioni al colletto di C. scoparium e di P. nicotianae spesso sono concomitanti.

Phytophthora nicotianae
Sinonimi: Phytophthora parasitica, P. nicotianae var. parasitica
Isolata per la prima volta da piante di tabacco alla fine del 19esimo secolo.
Organi colpiti: radici, fusti, tronco, foglie, frutti, baccelli.
Agente di: marciume zonato, gambo nero del tabacco, damping-off, marciumi della chioma, peronospora fogliare, marciumi dei frutti.
Ospiti: ampia gamma di ospiti, 25 generi compresi in 90 famiglie.
Phytophthora nicotianae
Sinonimi: Phytophthora parasitica, P. nicotianae var. parasitica

Sintomi in vivaio: non frequenti, possono manifestarsi a livello del colletto e delle radici con imbrunimenti e marciumi con conseguente riduzione della vigoria e morte delle piante. Il patogeno
non attacca le foglie.

Malattie da Phytophthora spp. in dettaglio

Phytophthora nicotianae
Sinonimi: Phytophthora parasitica, P. nicotianae var. parasitica
Sintomi in fase produttiva: prevalenza su frutti che appoggiano sul terreno, maculature a circoli concentrici, da cui prende nome la malattia (marciume zonato).
Macchie sui frutti di colore brunastro o grigio-verdastro ed interessano le bacche ancora verdi.

Malattie da Phytophthora spp. in dettaglio
Phytophthora nicotianae
Sinonimi: Phytophthora parasitica, P. nicotianae var. parasitica

Sul fusto l'infezione si presenta sotto forma di lesioni
brunastre che tendono a raggiungere i tessuti vascolari, causando il collasso delle parti soprastanti.
Negli ambienti molto umidi è anche possibile osservare, sugli organi colpiti, il micelio del fungo.


Phytophthora nicotianae
Sinonimi: Phytophthora parasitica, P. nicotianae var. parasitica
Epidemiologia:
- sopravvive nel terreno per mezzo degli organi di resistenza (clamidospore, oospore). - può rimanere vitale per molto tempo.
- Per lo sviluppo della malattia necessarie temperature del suolo di 18-30°C (optimum 27°C) ed elevata umidità.
La saturazione idrica del terreno stimola la liberazione delle zoospore che, diffuse nell'ambiente dagli schizzi di pioggia, diffondono la malattia.
Con condizioni termo-igrometriche ottimali, il periodo di incubazione della malattia è di soli 3-4 giorni.

Phytophthora nicotianae
Sinonimi: Phytophthora parasitica, P. nicotianae var. parasitica
Difesa: se le linee guida sulla produzione vivaistica sono osservate la malattia difficilmente può manifestarsi in vivaio.
Consigliato utilizzo di substrati e contenitori nuovi o sterilizzati e isolati dal terreno.
Rotazione e solarizzazione se la semina è direttamente al suolo.
Sterilizzazione delle acque di irrigazione
Intervento chimico solo alla comparsa dei sintomi.
Trattamenti eseguiti contro la peronospora normalmente sono sufficienti per contenere questa avversità, ma non ad eliminare il patogeno!!!!
Malattie da Phytophthora spp. in dettaglio
Phytophthora cactorum
Sinonimi: Peronospora cactorum, Nozemia cactorum, Phytophthora paeoniae

Osservato per la prima volta su specie di cactus nel 1870.
Organi colpiti: radici, foglie, fusti, frutti.
Agente di: marciumi ai frutti, foglie, fusto, colletto, corona e marciume radicale.
Ospiti: almeno 154 generi di piante vascolari distribuite in 54 famiglie.
Tra le specie di interesse vivaistico ci sono fragola, melo, orchidee e rododendro.


Phytophthora cactorum
Sinonimi: Peronospora cactorum, Nozemia cactorum, Phytophthora paeoniae
Sintomi:
- atrofia dei germogli
- riduzione dell’apparato radicale e una decolorazione nera delle radici.
- lesioni di colore marrone scuro dai bordi netti sui tessuti.
- sopra l'innesto e sulle foglie, si manifestano lesioni irregolari di colore marrone scuro.

Phytophthora cactorum
Sinonimi: Peronospora cactorum, Nozemia cactorum, Phytophthora paeoniae
Esempio su fragola:
- collasso delle piante e un profondo scolorimento rosso scuro della corona.
- arresto della crescita delle piante e appassimento delle foglie giovani sono i primi sintomi e possono comparire in qualsiasi momento durante la stagione.
- le piante infette stentate, l’intera pianta può appassire rapidamente fino al collasso totale.
- su foglie imbrunimento dei margini fogliari che spesso progredisce tra le vene.

Phytophthora cactorum
Sinonimi: Peronospora cactorum, Nozemia cactorum, Phytophthora paeoniae
Epidemiologia:
- sopravvive nel terreno per svariati anni, anche come saprofita.
- inoculo dai frutti caduti a terra e residui vegetali contaminati.
- le infezioni si diffondono con le lavorazioni e l’acqua circolante nel terreno.
La pacciamatura, mantenendo umido il terreno favorisce l’attacco del patogeno, come pure l’irrigazione a goccia, per effetto della quale è mantenuta frequentemente bagnata la zona intorno al colletto.
Le infezioni avvengono con penetrazione del patogeno attraverso le lenticelle o ferite di qualsiasi origine.

Phytophthora cactorum
Sinonimi: Peronospora cactorum, Nozemia cactorum, Phytophthora paeoniae
Difesa:
- lotta è di tipo preventivo agronomico ma si possono anche effettuare trattamenti chimici limitati ai primi stadi della malattia (metalaxil, sali di rame, fosetil alluminio). - adottare misure igieniche come pulire macchine e utensili, distruggere i cumuli di residui, rimuovere le radici residue e le foglie infestate. - evitare un'irrigazione eccessiva e fare attenzione con l'irrigazione a pioggia. - assicurare una rapida asciugatura e guarigione delle ferite.

Phytophthora cinnamomi
In Europa è arrivata probabilmente intorno al 19° secolo in vivaio.
Organi colpiti: radici, fusti, rami, durame.
Agente di: marciume radicale, cancri del fusto, appassimenti; causa il mal dell'inchiostro del castagno insieme a Phytophthora cambivora.
Ospiti: 266 generi distribuiti in 90 famiglie, comunemente alberi di latifoglie e conifere.
Colpisce Castagno, Faggio, Quercia, Noce, Ontano, Avocado,Ananas, etc.
Phytophthora cinnamomi

Agente causale della moria della quercia (1) e dell’eucalipto (2).
Presente in misura sempre crescente nei nostri castagneti e in contesti ornamentali.

Viene isolata anche in substrati per invasatura e acque di percolazione del vaso, dimostrando una presenza pervasiva nel vivaio.


Phytophthora cinnamomi
Imbrunimenti su tronco di quercia rossa da P. cinnamomi.


Malattie da Phytophthora spp. in dettaglio Phytophthora cinnamomi

Phytophthora cinnamomi

Sintomi:
- inizialmente localizzati sulle foglie, con macchie marroni che presto seccano, assumendo un color paglierino.
- in seguito blocco dello sviluppo della pianta, con avvizzimenti evidenti.
- sintomi che progrediscono dall’alto verso il basso.
- nuove foglie scarse e più piccole.
- i rami laterali iniziano a seccare, con conseguente caduta foglie.
- lacerazioni e fuoriuscita di liquido nerastro dal legno.
- morte della pianta.
Phytophthora cinnamomi
Epidemiologia:
- produce zoospore, clamidospore e oospore.

- le zoospore si muovono sfruttando l’acqua contenuta nel terreno, fino ad arrivare alle radici
sulle quali avviene la germinazione, seguita dalla penetrazione nell’arco delle 24 ore.
- Si diffonde nelle radici causandone il marciume, che si estende fino al colletto.
- Il micelio può sopravvivere 6 anni nel terreno umido.
- La dispersione a lungo raggio avviene mediante suolo o piante infette, ad opera dell’uomo.
- sensibile al freddo e piuttosto termofila, con una temperatura minima per la crescita di 5-6 °C, con un ottimo tra i 24-28 °C e un massimo tra i 32-34°C.
Phytophthora cinnamomi

Lotta:
- di tipo preventivo.
- Da un punto di vista selvicolturale si tende ad evitare i ristagni d’acqua ed eliminare e distruggere tutte le parti vegetali infette.
Lotta chimica:
- disinfezione dei tagli e ferite vicine al terreno ed interventi localizzati nelle prime fasi di sviluppo del patogeno con prodotti a base di rame.
- Il fosetyl-Al è stato il primo fungicida registrato in Francia per combattere questo patogeno. Eccellenti risultati nei primi anni di utilizzo. Negli anni ‘80, alcuni vivaisti hanno lamentato un’efficacia bassa e in alcuni casi nulla.
Phytophthora cinnamomi

Principi attivi utilizzabili:
- Metalaxyl
- Furalaxyl
- Benalaxyl - oxadixyl
- fosfonati, come Fosetyl-Al
- carbammati come propamocarb, - ditiocarbammati come zineb, mancozeb, tiram
- sali di rame (ossicloruro di rame, idrossido di rame, solfato di rame, poltiglia bordolese).

Deperimento di alberi di Quercus suber causati da P. cinnamomi in una piantagione in Sardegna (foto di Bruno Scanu e Antonio Franceschini. Università degli Studi di Sassari).

Phytophthora cinnamomi

Lesioni da marciume del colletto e morte di radici laterali causate da P. cinnamomi su Quercus
suber in Sardegna (foto di Bruno
Scanu e Antonio Franceschini)

Malattie da Phytophthora spp. in dettaglio

Phytophthora spp
Danni da Phytophthora spp.: (A) pino, (B) marciume radicale di ginepro (a destra) rispetto alla pianta sana (a sinistra), (C) peronospora fogliare di agrifoglio, (D) deperimento azalea, (E) morte cipresso calvo.


Potted plants with Symptomatic leaves
Damaged roots
) MGB TaqMan Assay
MGB TaqMan assay


Potted plants with Asymptomatic leaves
Undamaged roots
Isolation by baiting
I s o l a ti o n b y b a i ti n g



Isolation by baiting


Metabarcoding
Isolamenti

➢

campionamento

campioni sintomatici provenienti da 2 vivai
RADICI


FLOW THROUGH (acqua di imbibizione percolata)

Campionamento
Metabarcoding

➢ ESTRAZIONE DEL DNA PER METABARCODING (ACQUA E RADICI)


44 campioni (in triplicato 132):
-19 di acqua (7 di vivaio, 12 di flow through);
-25 di radici (13 di vivaio, 12 di flow-through)


Campionamento Metabarcoding
Isolamenti

➢ BAITING dall’inglese «bait», esca


Metabarcoding Isolamenti

Campionamento
Metabarcoding
Isolamenti
Sequenziamento del DNA ➢
Primer forward ITS6 5’-GAAGGTGAAGTCGTAACAAGG-3’
Primer reverse ITS4 5’-TCCTCCGCTTATTGATATGC-3’


Campionamento
Metabarcoding
Isolamenti
Sequenziamento del DNA
➢ SEQUENZIAMENTO (Sanger)

P. cinnamomi
P. nicotianae
P. citrophthora
P. gonapodides
P. lacustris
P. plurivora
P. pseudocryptogea
P. multivora
P. hydropatica
P. crassamura/megasperma
P. cactorum
P. cambivora
P. chlamydospora
Phytopythium sp.
Phytopythium vexans
Acqua Suolo e Radici
M1N2 Magnolia H2O X
M1N2 C concha terra X
M2N2 C concha H2O X
M4N2 C concha H2O X
M1N2 E ang. terra X
M2 N2 E ang. terra X
M1N2 C azt. terra X
M2N2 C azt. terra X
M1N2 C tern. H2O X
M3N2 C concha H2O X
M1N2 fosso H2O X
M4N2 fosso H2O X
M10N2 fosso H2O X
M7N2 fosso H2O X
M6N2 fosso H2O X
M8N2 fosso H2O X
M2N2 pozze H2O X
M2N2 fosso H2O X
M3N2 fosso H2O X
M5N2 fosso H2O X
M3N2 Magnolia H2O X
M4N2 C azt. H2O X
M5N2 C azt. H2O X
M1N2 C azt. H2O X
M2N2 C azt. H2O X
M3N2 C azt. H20 X
M2N2 C concha terra X
M9N2 fosso H2O X
M1N2 pozze H2O X
M3N2 C concha terra X
M12N2 fosso H2O X
M11N2 fosso H2O X
M1N1 V tinus X
M2N1 C semper. A X
Pythiumsp. M1N1 lago X

Campionamento
Metabarcoding
Isolamenti
Sequenziamento del DNA
Considerazioni finali


Campionamento
Metabarcoding
Isolamenti
Sequenziamento del DNA
Considerazioni finali
